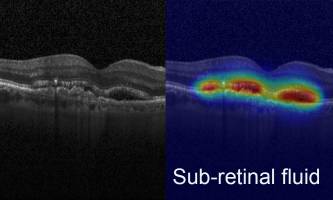
Advanced AI boosts clinical analysis of eye images

news
University of Bern
Results 201 - 220 of 342.
Astronomy & Space - Physics - 15.01.2020

Phosphorus, present in our DNA and cell membranes, is an essential element for life. But how it became available on the early Earth when life appeared here about 4 billion years ago is something of a mystery. For the first time, astronomers - among them researchers from the University of Bern - have now been able to show that molecules with phosphorus are formed in star-forming regions and probably came to Earth with comets.
Health - Pharmacology - 13.01.2020

People with mechanical heart valves need blood thinners on a daily basis, because they have a higher risk of blood clots and stroke. Researchers at the ARTORG Center of the University of Bern, Switzerland, now identified the root cause of blood turbulence leading to clotting. Design optimization could greatly reduce the risk of clotting and enable these patients to live without life-long medication.
Life Sciences - 20.12.2019
Identifications of neurons responsible for rapid eye movements (REM) during sleep
Why do we move our eyes fast in the paradoxical sleep - in that sleep phase, in which most dreams take place? The secret is not yet fully aired, but we are on his track: A team of researchers has identified the nerve cells behind this curious phenomenon. REM - Rapid Eye Movement - is not only the name of a successful American rock band, but also and not least a characteristic eye movement in paradoxical sleep, so in the stage with high dream activity.
Health - Life Sciences - 20.12.2019

Pathogens can drive the evolution of social behaviour in insects. This is shown by researchers from Bern and Würzburg for ambrosia beetles. Ants and honeybees share nests of hundreds or thousands of individuals in a very small space. Hence the risk is high that infectious diseases may spread rapidly.
Health - Life Sciences - 19.11.2019

Killer cells of the immune system detect and kill infected cells or cancer cells. Researchers at the Institute of Pathology at the University of Bern have now discovered that the mechanism by which certain immune cells kill their target cells can also be used to control the killer cells themselves. This finding may be relevant to cancer immunotherapy.
Life Sciences - Social Sciences - 15.11.2019

The western corn rootworm, one of the world's most damaging maize pests, can use plant defense compounds to defend itself against its own natural enemies, so-called entomopathogenic nematodes. However, the nematodes can become immune against these compounds in turn, which enhances their ability to fight the western corn rootworm, as researchers at the University of Bern show.
Life Sciences - Health - 14.11.2019

An international scientific consortium led by the cell biologists Volker Heussler from the University of Bern and Oliver Billker from the Umeå University in Sweden has for the first time systematically investigated the genome of the malaria parasite Plasmodium throughout its life cycle in a large-scale experiment.
Health - Pharmacology - 31.10.2019

Many liver tumors have long been difficult or impossible to remove. Since 2015, however, it has been possible to treat these tumors by combining noninvasive surgical techniques, radiological imaging and a navigation system. For the first time, a new study by University of Bern and Inselspital, Berne University Hospital has impressively demonstrated the success of this technique.
Health - Life Sciences - 23.10.2019

It is already known that zebrafish can flexibly regenerate their hearts after injury. An international research group led by Prof. Nadia Mercader of the University of Bern now shows that certain heart muscle cells play a central role in this process. The insights gained could be used to initiate a similar repair process in the human heart.
Astronomy & Space - Environment - 09.10.2019

A hot, molten Earth would be around 5% larger than its solid counterpart. This is the result of a study led by researchers at the University of Bern. The difference between molten and solid rocky planets is important for the search of Earth-like worlds beyond our Solar System and the understanding of Earth itself.
Astronomy & Space - Physics - 26.09.2019

Astronomers detected a giant planet orbiting a small star. The planet has much more mass than theoretical models predict. While this surprising discovery was made by a Spanish-German team at an observatory in southern Spain, researchers at the University of Bern studied how the mysterious exoplanet might have formed.
Health - Pharmacology - 19.09.2019
A fast and reliable machine learning tool, developed by the ARTORG Center, University of Bern and the Department of Ophthalmology, Inselspital brings Artificial Intelligence (AI) closer to clinical use in Ophthalmology. The novel method published in Nature Scientific Reports on September 19, 2019 presents a tool that reliably extracts meaning from extensive image data.
Life Sciences - Health - 18.09.2019

Scientists at EPFL's Swiss Institute for Experimental Cancer Research and University of Bern have discovered a signaling pathway that breast tumors exploit to metastasize to the brain. In 2018, breast cancer was the most common cancer in women worldwide, accounting for about a quarter of all reported cancers.
Health - Pharmacology - 18.09.2019

A reliable prognosis for coma patients in the intensive care unit is crucial. Improved transparency will boost the use of Artificial Intelligence (AI) to support end-of-life decisions. For the first time, a research team has succeeded in identifying specific patterns in Electro-Encephalogram (EEG) analyses that the deep-learning network uses for making prognosis decisions.
Environment - Social Sciences - 11.09.2019

A world without poverty, in which everyone's well-being is ensured: achieving this goal by 2030 is still possible, but only if the relationship between people and nature is fundamentally changed and social inequalities are reduced. That is the conclusion of the 2019 UN Global Sustainable Development Report, drafted by an independent group of scientists co-chaired by Peter Messerli, University of Bern, and Endah Murniningtyas.
Astronomy & Space - Earth Sciences - 29.08.2019

A rocky extrasolar moon (exomoon) with bubbling lava may orbit a planet 550 light-years away from us. This is suggested by an international team of researchers led by the University of Bern on the basis of theoretical predictions matching observations. The "exo-Io" would appear to be an extreme version of Jupiter's moon Io.
Environment - History & Archeology - 24.07.2019

In contrast to pre-industrial climate fluctuations, current, anthropogenic climate change is occurring across the whole world at the same time. In addition, the speed of global warming is higher than it has been in at least 2,000 years. That's according to two studies from the University of Bern. Many people have a clear picture of the "Little Ice Age" (from approx. 1300 to 1850).
Environment - Earth Sciences - 24.07.2019

Five large volcanic eruptions occurred in the early 19th century. They caused cooling and - as a study led by the University of Bern shows - to drying in the monsoon regions and glaciers growing in the Alps. The study shows that the pre-industrial climate was not constant: if one takes this cold period as the starting point for current global warming, the climate has already warmed up more than assumed in the current discussions.
Health - Career - 17.07.2019

The University of Bern and the Diabetes Center Berne (DCB) are together creating four professorships in the field of diabetes technology research and development. This will boost the international profile of diabetes research in Bern and strengthen its role as a center of medicine in the long term. The four professorships are to be financed with 417,000 Swiss francs per annum each over a period of 12 years.
Health - Life Sciences - 20.06.2019

For the first time, Bernese researchers have been able to solve the structure of a transport protein and thus to describe the functional mechanism that plays a significant role in the survival of cancer cells. This is an important step towards developing effective inhibitors and fight tumor growth. Certain cancer cells depend on exporting the metabolite lactate, which accumulates during the generation on energy.
Event - Mar 17
CEA Leti to Showcase Integrated Expertise In Microelectronics Reliability at IRPS 2026
CEA Leti to Showcase Integrated Expertise In Microelectronics Reliability at IRPS 2026
Health - Mar 17
AI was supposed to ease doctors' workload - instead they spend hours correcting errors
AI was supposed to ease doctors' workload - instead they spend hours correcting errors
Pharmacology - Mar 17
International trial finds rapid diagnostic testing alone does not reduce antibiotic prescribing for respiratory infections
International trial finds rapid diagnostic testing alone does not reduce antibiotic prescribing for respiratory infections
Social Sciences - Mar 17
Social background shapes how hard children work, according to a study by UC3M
Social background shapes how hard children work, according to a study by UC3M

Innovation - Mar 17
With Robotics Innovation Center, CMU and Hazelwood Partners Sustain Community Collaborations
With Robotics Innovation Center, CMU and Hazelwood Partners Sustain Community Collaborations















